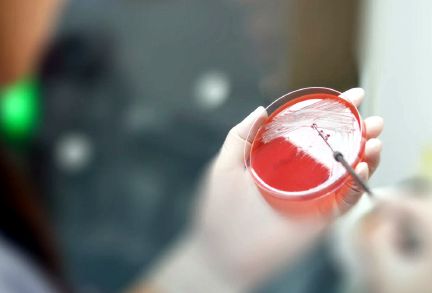
SALUD

Informe pone de relieve el aumento de la resistencia a los antibióticos en infecciones bacterianas que afectan al ser humano
9 de diciembre de 2022, Ginebra — Un nuevo informe de la Organización Mundial de la Salud (OMS) pone de manifiesto elevados niveles de resistencia en bacterias causantes de septicemias potencialmente mortales, así como una creciente resistencia a los tratamientos en varias bacterias que provocan infecciones comunes entre la población, según se desprende de los datos comunicados por 87 países en 2020.
Por primera vez, en el informe del Sistema Mundial de Vigilancia de la Resistencia a los Antimicrobianos y de su Uso (GLASS) se analizan las tasas de resistencia a los antimicrobianos (o antibiorresistencia) en relación con la cobertura de pruebas analíticas en cada país, así como las tendencias al respecto desde 2017 y datos sobre el consumo humano de antimicrobianos en 27 países. En seis años se ha logrado que participen en el GLASS 127 países, que representan a un 72% de la población mundial. El informe se presenta también en un innovador formato digital interactivo que facilita la extracción de datos y la elaboración de gráficos.
El informe revela que se describieron y notificaron elevados niveles de resistencia (por encima del 50%) en bacterias que son causa frecuente de septicemia en hospitales, como Klebsiella pneumoniae o Acinetobacter spp. Para tratar estas infecciones potencialmente mortales se precisan antibióticos de último recurso, como los carbapenémicos. Según los datos comunicados, sin embargo, un 8% de las septicemias causadas por Klebsiella pneumoniae se mostraron resistentes a los carbapenémicos, lo que aumenta el riesgo de muerte por una infección no tratable.
Las infecciones bacterianas comunes presentan cada vez mayor resistencia a los tratamientos. Más del 60% de las cepas aisladas de Neisseria gonorrea, causante de una frecuente enfermedad de transmisión sexual, han mostrado resistencia a uno de los antibacterianos más utilizados por vía oral, la ciprofloxacina. Más del 20% de las cepas aisladas de E. coli, que es el patógeno más común en las infecciones de las vías urinarias, resultaron resistentes tanto a los fármacos de primera línea (ampicilina y cotrimoxazol) como a los tratamientos de segunda línea (fluoroquinolonas).
«La resistencia a los antimicrobianos erosiona la medicina moderna y pone millones de vidas en peligro,» afirmó el Dr. Tedros Adhanom Ghebreyesus, Director General de la OMS. «Para aprehender realmente la magnitud de la amenaza mundial y organizar una respuesta de salud pública eficaz contra las antibiorresistencias debemos multiplicar los análisis microbiológicos y generar datos de calidad garantizada en todos los países, y no solo en los más ricos.»
Aunque en los últimos 4 años la mayoría de las tendencias al respecto se han mantenido estables, las septicemias causadas por cepas resistentes de Escherichia coli y Salmonella spp. y las gonorreas resistentes han aumentado en por lo menos un 15% en comparación con los niveles de 2017. Se requieren más investigaciones para descubrir las razones que subyacen a esta progresión de las antibiorresistencias y para saber en qué medida ello guarda relación con el mayor número de hospitalizaciones y de tratamientos antibióticos registrado durante la pandemia de COVID-19. La pandemia también impidió a varios países comunicar los datos correspondientes a 2020.
Los nuevos análisis muestran una mayor probabilidad de que los países con menor cobertura de pruebas analíticas, que suelen ser países de renta baja o renta media, comuniquen tasas de resistencia a los antibacterianos significativamente más altas para la mayoría de las combinaciones «germen-fármaco», lo que (en parte) puede atribuirse al hecho de que en muchos países de renta baja o renta media haya solo unos pocos hospitales de referencia que transmiten datos al GLASS. Estos hospitales suelen atender a los pacientes más enfermos, que pueden haber recibido tratamiento antibiótico previo.
A modo de ejemplo, cabe señalar que el nivel medio mundial de antibiorresistencias en E. Coli y en Staphylococcus aureus resistente a la meticilina (los dos microorganismos utilizados como indicador al respecto en los Objetivos de Desarrollo Sostenible) fue, respectivamente, de un 42% y de un 35%. Pero al considerar solamente a los países con elevada cobertura de pruebas analíticas, los niveles obtenidos fueron bastante inferiores: un 11% y un 6,8% más bajos, respectivamente.
Por lo que respecta al consumo humano de antimicrobianos, el 65% de los 27 países comunicantes habían cumplido el objetivo de la OMS de lograr que al menos un 60% de los antimicrobianos consumidos fueran del grupo «Acceso» de antibióticos, es decir, aquellos que, según la clasificación AWaRE de la OMS, son eficaces contra un amplio espectro de infecciones comunes y entrañan un riesgo relativamente bajo de generar resistencia.
Debido a la insuficiente cobertura de las pruebas analíticas y a la escasa capacidad de laboratorio, especialmente en los países de renta baja y renta media, sigue resultando difícil interpretar las tasas de resistencia a los antimicrobianos. Para solventar esta carencia crítica, la OMS seguirá una doble línia de trabajo: a corto plazo, obtener datos probatorios por medio de encuestas; a largo plazo, generar capacidad de vigilancia sistemática. Ello se traducirá, por un lado, en la implantación de encuestas representativas a escala nacional sobre la prevalencia de antibiorresistencias, con el fin de generar un acervo de datos de referencia y datos de tendencia en la materia que sirvan para formular políticas y seguir de cerca las intervenciones y, por otro lado, en un aumento, en todos los niveles del sistema de salud, del número de laboratorios con garantía de calidad que comuniquen datos representativos sobre antibiorresistencias.
Para hacer frente al curso creciente de las antibiorresistencias es preciso que los países pongan el mayor empeño, a alto nivel, en potenciar su capacidad de vigilancia y aportar datos de calidad garantizada, sabiendo que también incumbe actuar a todas las personas y comunidades. La próxima fase del GLASS, al potenciar la recogida de datos normalizados y de calidad sobre la resistencia a los antimicrobianos y el consumo de estos fármacos, cimentará una actuación eficaz y científicamente sólida para atajar la aparición y propagación de antibiorresistencias y proteger el uso de medicamentos antimicrobianos para las futuras generaciones.
